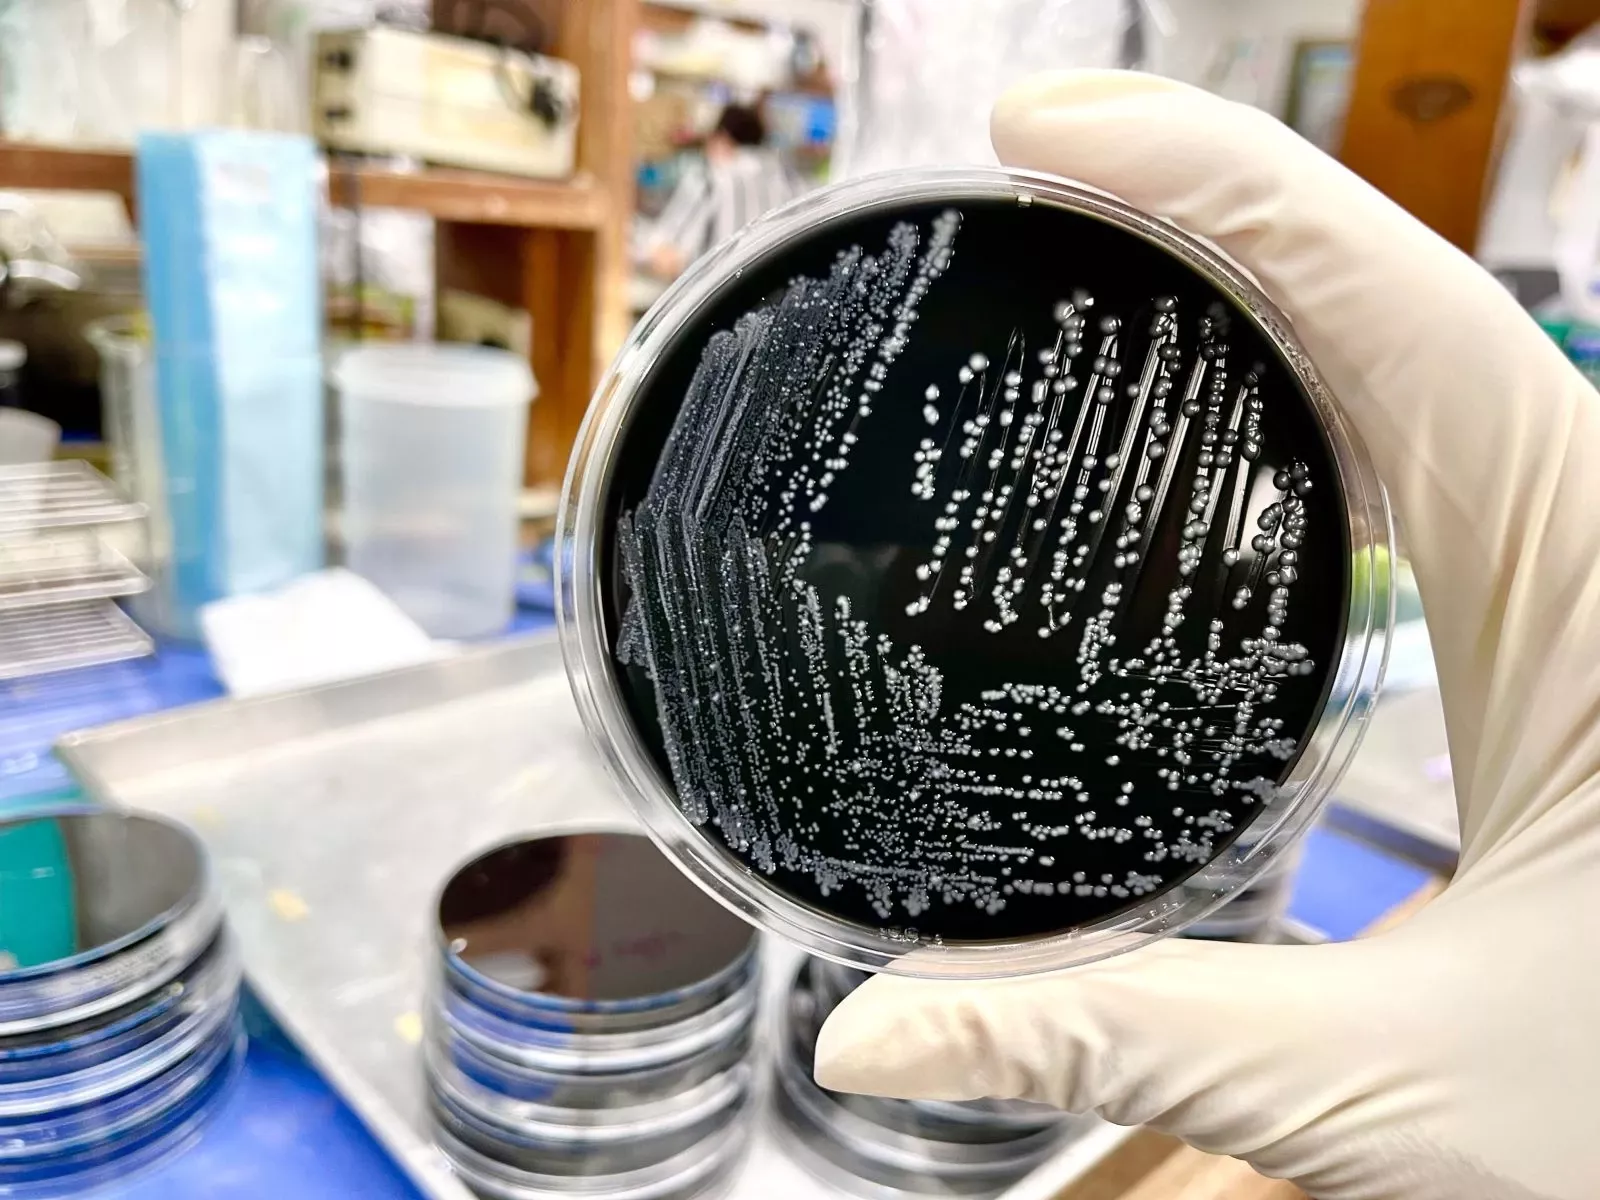

Dünya
Milyonlarla insanı təhdid edən təhlükə: Xilas üçün yalnız bir yol var
Antibiotiklərə davamlı bakteriyalar olan superböcəklərin səbəb olduğu ölümlərin 2050-ci ilə qədər 60 faiz artacağı proqnozlaşdırılır.
Publika.az xəbər verir ki, bu barədə “The Guardian” məlumat yayıb.
Böyük Britaniyada aparılan araşdırma nəticəsində məlum olub ki, bu təhlükə qlobal səhiyyə və iqtisadiyyatda dərin iz buraxacaq.
Alimlərin hesablamalarına görə, tədbirlər görülmədiyi təqdirdə bakteriyaların antibiotiklərə davamlılığı (AMR) hər il dünya ümumi daxili məhsuluna (ÜDM) 1,7 milyard dollar zərər vura bilər. Sağlamlığın Ölçüləri və Qiymətləndirilməsi İnstitutu da (IHME) xəbərdarlıq edir ki, 2050-ci ilə qədər yalnız ABŞ-da 1,34 milyon, Böyük Britaniyada isə 184 min insan bu infeksiyalardan dünyasını dəyişəcək.

Antibiotiklərə davamlı bakteriyalar xəstəxanaya yerləşdirmə hallarının artmasına və müalicələrin bahalaşmasına səbəb olur. Tədqiqat göstərir ki, davamlı infeksiyaların müalicəsi adi infeksiyalardan təxminən iki dəfə baha başa gəlir.
Hesablamalara əsasən, qlobal səhiyyə xərcləri hər il 176 milyard dollara qədər arta bilər. Təkcə ABŞ-da bu rəqəm 57 milyard dollar, Böyük Britaniyada isə 3,7 milyard dollar ola bilər.
Qlobal İnkişaf Mərkəzinin apardığı araşdırma nəticəsində məlum olub ki, ABŞ, Böyük Britaniya və Avropa İttifaqı bu problemdən ən çox zərər görəcək bölgələr olacaq.
Tədqiqatın müəllifi Entoni MakDonnellin sözlərinə görə, hətta hazırda müsbət nəticələr əldə edən ölkələr belə gələcəkdə risk altındadır. O qeyd edib ki, yardım proqramları davam etməzsə, antibiotik müqaviməti sürətlə artacaq və dünyanın hər yerində milyonlarla insanın ölümünə səbəb olacaq.
Roza
-
Sosial04:44105 yaşlı Nazxanım nənə VƏFT ETDİ
-
Səhiyyə02:42Yayılan virusa görə məktəblər bağlana bilər? - MÜTDA-dan AÇIQLAMA
-
Region02:12SON DƏQİQƏ: Etirazçılar SEPAH-ın binasını yandırdılar
-
Sosial01:30Bakıda yaşayış binasında YANĞIN: Ağır xəsarət alan var - VİDEO/YENİLƏNDİ
-
Qoroskop00:15Günün ULDUZ FALI - Gizli qalan həqiqətlər üzə çıxacaq
-
Sosial8 Yanvar 23:36Reabilitasiya Mərkəzindən qaçan Nəsimi Nəbizadə görün harada gizlənir - YENİLƏNDİ
-
ABŞ8 Yanvar 23:00Azərbaycanlı gənc ABŞ-də İTKİN DÜŞDÜ
-
Magazin18 Yanvar 22:48Elnarə Abdullayeva onun cavabını efirdən verəcək - “Gözdə-qulaqda olun”
















.jpg)













